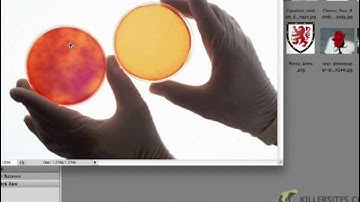
Photoshop CS5 Closed Captioned - Open Files and Bridge

⬇ DOWNLOAD NOW
Kalau muncul iklan pop-up, tutup lalu klik tombol kembali
Download lagu Photoshop CS5 - Open Files and Bridge secara gratis hanya untuk keperluan promosi. Dukung artis favorit kamu dengan membeli musik original di iTunes atau platform resmi lainnya.
Photoshop CS5 Closed Captioned - Open Files and Bridge
Photoshop CS5 Closed Captioned - Open Files and Bridge
 Opening Files in Photoshop from Bridge
Opening Files in Photoshop from Bridge
 How to open file in adobe photoshop cs5
How to open file in adobe photoshop cs5
![Photoshop CS5- What is Adobe Bridge? [1/8 in "It Begins in Bridge"]](https://i.ytimg.com/vi/tqlVgjSb5lA/hq720.jpg?sqp=-oaymwE9COgCEMoBSFryq4qpAy8IARUAAAAAGAElAADIQj0AgKJDeAHwAQH4Af4JgALQBYoCDAgAEAEYciBIKDQwDw==&rs=AOn4CLAnuBQug4pNAl0tFwzMQ4BQZ3ghfg) Photoshop CS5- What is Adobe Bridge? [1/8 in "It Begins in Bridge"]
Photoshop CS5- What is Adobe Bridge? [1/8 in "It Begins in Bridge"]
 Photoshop for Beginners Video 2 - Opening a File and Using Adobe Bridge
Photoshop for Beginners Video 2 - Opening a File and Using Adobe Bridge
 First Steps in Photoshop CS5 Open Edit Save Images
First Steps in Photoshop CS5 Open Edit Save Images
 Adobe Photoshop CS5 & Bridge Workflow Photoset Edit Process
Adobe Photoshop CS5 & Bridge Workflow Photoset Edit Process
 Mini Bridge View Options(Adobe Photoshop CS5 Pro) Part4
Mini Bridge View Options(Adobe Photoshop CS5 Pro) Part4